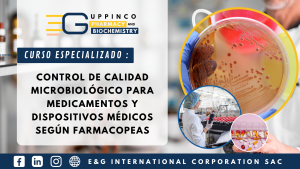
9

Farmacia y Bioquímica
Bienvenidos a la Sección de Cursos de Farmacia y Bioquímica, ofrecidos por UPPINCO, donde nos enorgullece brindar educación de vanguardia en ciencias farmacéuticas y bioquímicas. Nuestros programas están diseñados para nutrir y potenciar las habilidades de los profesionales en estas disciplinas, desde conceptos fundamentales hasta las últimas innovaciones. Con instructores altamente calificados y contenido actualizado, nuestros cursos abarcan temas como desarrollo y formulación de medicamentos, análisis bioquímico y regulaciones farmacéuticas. Al elegir nuestros cursos, está invirtiendo en una formación integral que impulsará su carrera y lo mantendrá al tanto de los avances en estas áreas críticas. Únase a nosotros en este viaje educativo para alcanzar nuevas alturas en su campo y contribuir al progreso continuo en farmacia y bioquímica. ¡Comencemos a aprender y crecer con UPPINCO!